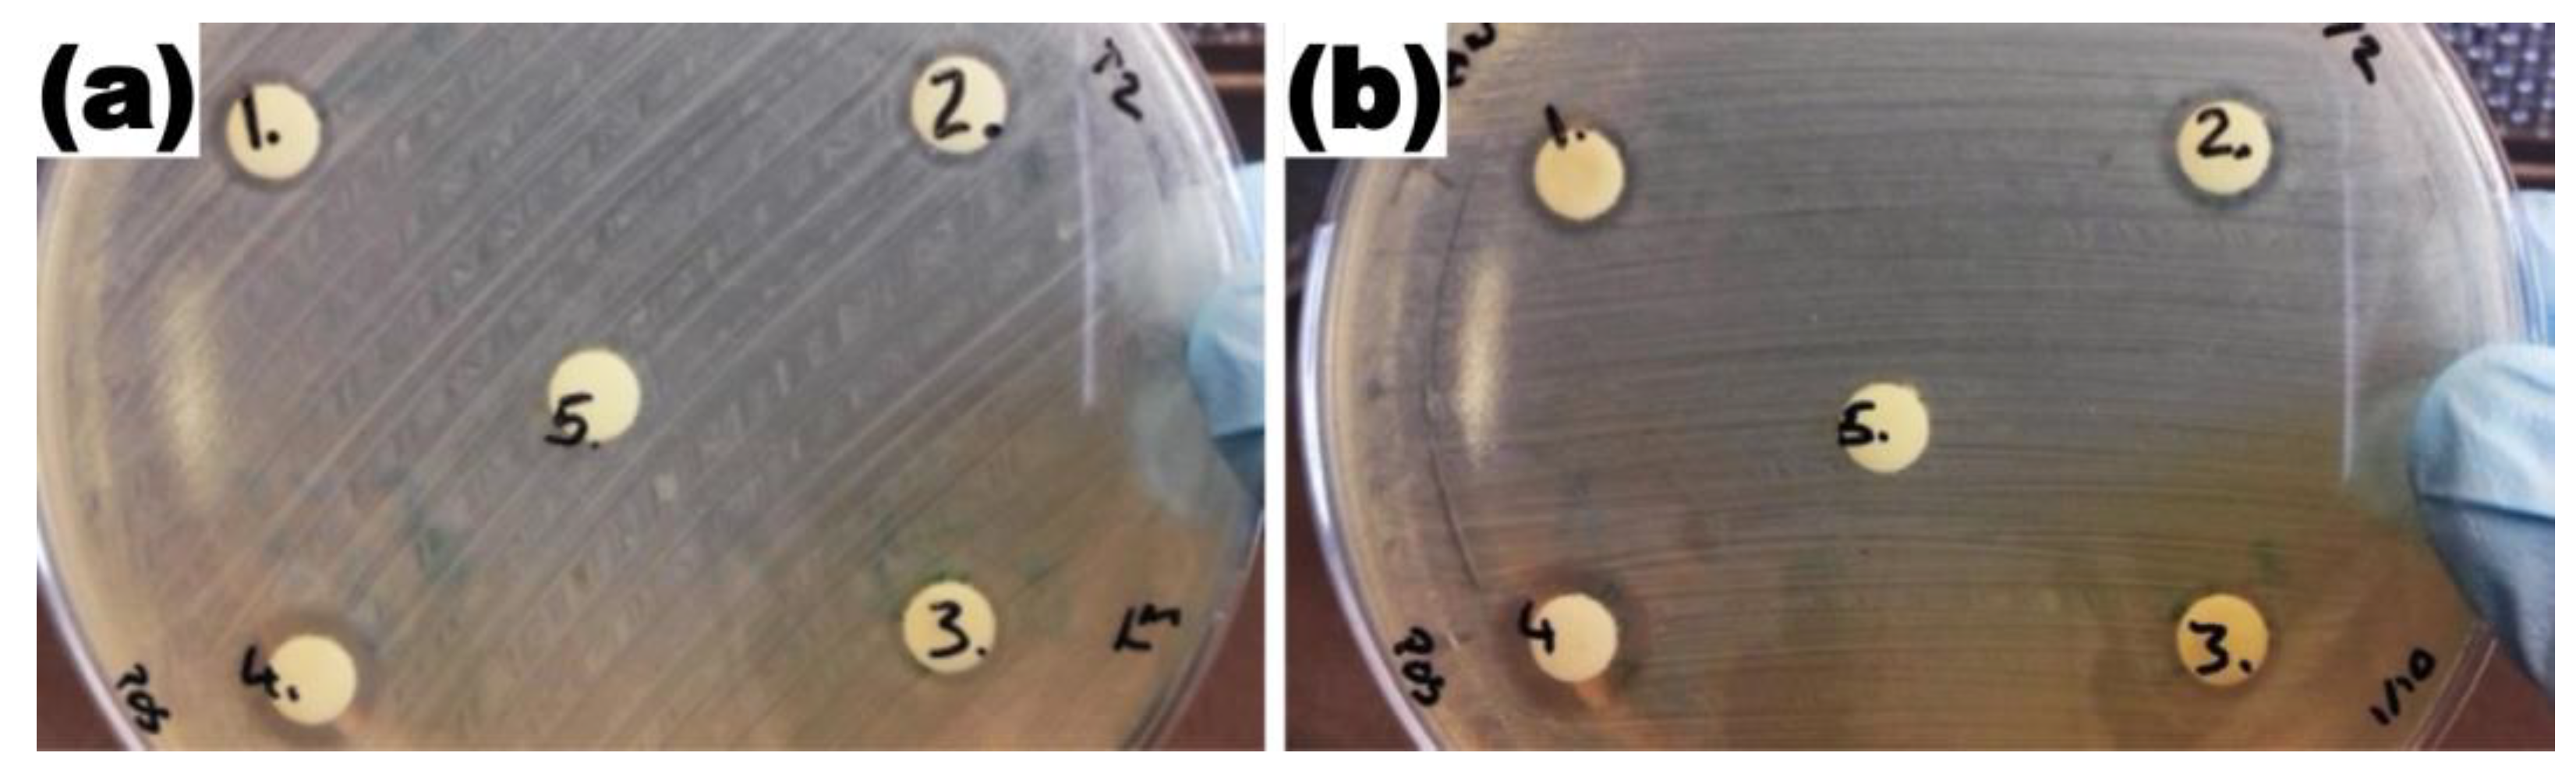

Production of Silver Nano-Inks and Surface Coatings for Anti-Microbial Food Packaging and Its Ecological Impact
Abstract
1. Introduction
2. Results and Discussion
2.1. Characterisation of Silver Nanoparticles
2.2. Antibacterial Activity of Silver Nanoparticles
2.3. Rheological Properties of Silver Nano-Ink
2.4. Inkjet Printing of Silver Nano-Ink on Cyclo-Olefin Polymer (COP)
Antibacterial Activity and Ecotoxicity Analysis of Silver Nano-Ink Printed Polymer
2.5. Comparison with State-of-the-Art
3. Materials and Methods
3.1. Nanoparticle Production
3.1.1. Laser Synthesis in Solution (LASiS)
3.1.2. Ultrasonic Spray Pyrolysis (USP)
3.2. Characterisation Techniques
Nanoparticle Size and Morphology
3.3. Nano-Ink Formulation
3.4. Surface Coating and Inkjet Printing
3.5. Antibacterial Activity and Ecotoxicity Test
3.5.1. Agar Disc Diffusion Test for Antibacterial Activity of Silver Nanoparticles
3.5.2. Immersion Antibacterial Activity Testing of Silver Nanoink-Printed Polymer
3.5.3. Ecotoxicological Effects of Silver Printed Polymer
3.6. Statistical Analysis
4. Conclusions
Author Contributions
Funding
Institutional Review Board Statement
Informed Consent Statement
Data Availability Statement
Acknowledgments
Conflicts of Interest
References
- Abdul Hakeem, D.; Su, S.; Mo, Z.; Wen, H. Upconversion Luminescent Nanomaterials: A Promising New Platform for Food Safety Analysis. Crit. Rev. Food Sci. Nutr. 2021, 62, 8866–8907. [Google Scholar] [CrossRef]
- Zhang, M.; Lu, X.; Bai, J. The Effectiveness of Information Interventions to Improve Domestic Food Safety among Rural Consumers. Int. J. Consum. Stud. 2022, 47, 496–508. [Google Scholar] [CrossRef]
- Al-Tayyar, N.A.; Youssef, A.M.; Al-Hindi, R.R. Edible Coatings and Antimicrobial Nanoemulsions for Enhancing Shelf Life and Reducing Foodborne Pathogens of Fruits and Vegetables: A Review. Sustain. Mater. Technol. 2020, 26, e00215. [Google Scholar] [CrossRef]
- Wang, L.; Periyasami, G.; Aldalbahi, A.; Fogliano, V. The Antimicrobial Activity of Silver Nanoparticles Biocomposite Films Depends on the Silver Ions Release Behaviour. Food Chem. 2021, 359, 129859. [Google Scholar] [CrossRef] [PubMed]
- Azizi-Lalabadi, M.; Garavand, F.; Jafari, S.M. Incorporation of Silver Nanoparticles into Active Antimicrobial Nanocomposites: Release Behavior, Analyzing Techniques, Applications and Safety Issues. Adv. Colloid Interface Sci. 2021, 293, 102440. [Google Scholar] [CrossRef] [PubMed]
- Istiqola, A.; Syafiuddin, A. A Review of Silver Nanoparticles in Food Packaging Technologies: Regulation, Methods, Properties, Migration, and Future Challenges. J. Chin. Chem. Soc. 2020, 67, 1942–1956. [Google Scholar] [CrossRef]
- Mostafa, A.M.; Menazea, A.A. Polyvinyl Alcohol/Silver Nanoparticles Film Prepared via Pulsed Laser Ablation: An Eco-Friendly Nano-Catalyst for 4-Nitrophenol Degradation. J. Mol. Struct. 2020, 1212, 128125. [Google Scholar] [CrossRef]
- Bogovic, J.; Rudolf, R.; Friedrich, B. The Controlled Single-Step Synthesis of Ag/TiO2 and Au/TiO2 by Ultrasonic Spray Pyrolysis (USP). JOM 2016, 68, 330–335. [Google Scholar] [CrossRef]
- Sreenilayam, S.P.; McCarthy, É.; McKeon, L.; Ronan, O.; McCann, R.; Fleischer, K.; Freeland, B.; Nicolosi, V.; Brabazon, D. Additive-Free Silver Nanoparticle Ink Development Using Flow-Based Laser Ablation Synthesis in Solution and Aerosol Jet Printing. Chem. Eng. J. 2022, 449, 137817. [Google Scholar] [CrossRef]
- Bagga, K.; McCann, R.; Wang, M.; Stalcup, A.; Vázquez, M.; Brabazon, D. Laser Assisted Synthesis of Carbon Nanoparticles with Controlled Viscosities for Printing Applications. J. Colloid Interface Sci. 2015, 447, 263–268. [Google Scholar] [CrossRef]
- Kaya, E.E.; Kaya, O.; Alkan, G.; Gürmen, S.; Stopic, S.; Friedrich, B. New Proposal for Size and Size-Distribution Evaluation of Nanoparticles Synthesized via Ultrasonic Spray Pyrolysis Using Search Algorithm Based on Image-Processing Technique. Materials 2020, 13, 38. [Google Scholar] [CrossRef] [PubMed]
- Bahrami, A.; Delshadi, R.; Assadpour, E.; Jafari, S.M.; Williams, L. Antimicrobial-Loaded Nanocarriers for Food Packaging Applications. Adv. Colloid Interface Sci. 2020, 278, 102140. [Google Scholar] [CrossRef]
- Boumeganane, A.; Nadi, A.; Cherkaoui, O.; Tahiri, M. Inkjet Printing of Silver Conductive Ink on Textiles for Wearable Electronic Applications. Mater. Today Proc. 2022, 58, 1235–1241. [Google Scholar] [CrossRef]
- Söğüt, E.; Seydim, A.C. Characterization of Cyclic Olefin Copolymer-Coated Chitosan Bilayer Films Containing Nanocellulose and Grape Seed Extract. Packag. Technol. Sci. 2018, 31, 499–508. [Google Scholar] [CrossRef]
- Yamazaki, M. Industrialization and Application Development of Cyclo-Olefin Polymer. Proc. J. Mol. Catal. A Chem. 2004, 213, 81–87. [Google Scholar] [CrossRef]
- Raza, M.A.; Kanwal, Z.; Rauf, A.; Sabri, A.N.; Riaz, S.; Naseem, S. Size- and Shape-Dependent Antibacterial Studies of Silver Nanoparticles Synthesized by Wet Chemical Routes. Nanomaterials 2016, 6, 74. [Google Scholar] [CrossRef] [PubMed]
- Backman, L.; Gild, J.; Luo, J.; Opila, E.J. Part I: Theoretical Predictions of Preferential Oxidation in Refractory High Entropy Materials. Acta Mater. 2020, 197, 20–27. [Google Scholar] [CrossRef]
- Aguilera-Ruiz, E.; Zambrano-Robledo, P.; Vazquez-Arenas, J.; Cruz-Ortiz, B.; Peral, J.; García-Pérez, U.M. Photoactivity of Nanostructured Spheres of BiVO4 Synthesized by Ultrasonic Spray Pyrolysis at Low Temperature. Mater. Res. Bull. 2021, 143. [Google Scholar] [CrossRef]
- Freeland, B.; McCann, R.; Alkan, G.; Friedrich, B.; Foley, G.; Brabazon, D. Stable Nano-Silver Colloid Production via Laser Ablation Synthesis in Solution (LASiS) under Laminar Recirculatory Flow. Adv. Mater. Process. Technol. 2020, 6, 677–685. [Google Scholar] [CrossRef]
- McCarthy, É.; Sreenilayam, S.P.; Ronan, O.; Ayub, H.; McCann, R.; McKeon, L.; Fleischer, K.; Nicolosi, V.; Brabazon, D. Silver nanocolloid generation using dynamic Laser Ablation Synthesis in Solution system and drop-casting. Nano-Struct. Nano-Objects. 2022, 29, 100841. [Google Scholar] [CrossRef]
- Freeland, B.; Mccann, R.; O’neill, P.; Sreenilayam, S.; Tiefenthaler, M.; Dabros, M.; Juillerat, M.; Foley, G.; Brabazon, D. Real-Time Monitoring and Control for High-Efficiency Autonomous Laser Fabrication of Silicon Nanoparticle Colloids. Int. J. Adv. Manuf. Technol. 2021, 114, 291–304. [Google Scholar] [CrossRef]
- Rafique, M.; Rafique, M.S.; Kalsoom, U.; Afzal, A.; Butt, S.H.; Usman, A. Laser Ablation Synthesis of Silver Nanoparticles in Water and Dependence on Laser Nature. Opt. Quantum Electron. 2019, 51, 179. [Google Scholar] [CrossRef]
- Liao, C.; Li, Y.; Tjong, S.C. Bactericidal and Cytotoxic Properties of Silver Nanoparticles. Int. J. Mol. Sci. 2019, 20, 449. [Google Scholar] [CrossRef] [PubMed]
- Abdullahi, M.; Li, X.; Abdallah, M.A.E.; Stubbings, W.; Yan, N.; Barnard, M.; Guo, L.H.; Colbourne, J.K.; Orsini, L. Daphnia as a Sentinel Species for Environmental Health Protection: A Perspective on Biomonitoring and Bioremediation of Chemical Pollution. Environ. Sci. Technol. 2022, 56, 14237–14248. [Google Scholar] [CrossRef] [PubMed]
- Garcia, M.T.; Gathergood, N.; Scammells, P.J. Biodegradable Ionic Liquids Part II. Effect of the Anion and Toxicology. Green Chem. 2005, 7, 9–14. [Google Scholar] [CrossRef]
- Pavithran, S.S.; McCann, R.; McCarthy, É.; Freeland, B.; Fleischer, K.; Goodnick, S.; Bowden, S.; Honsberg, C.; Brabazon, D. Silver and Copper Nano-Colloid Generation via Pulsed Laser Ablation in Liquid: Recirculation Nanoparticle Production Mode. In Proceedings of the ESAFORM 2021—24th International Conference on Material Forming, Liège, Belgium, 14–16 April 2021. [Google Scholar]
- Cannon, P.; Freeland, B.; Jaquiery, M.; McGlynn, E.; Gaughran, J. Single-Step Functionalization of Silicon Nanoparticles Providing Efficient DNA Binding. Colloids Surf. A Physicochem. Eng. Asp. 2022, 648, 129217. [Google Scholar] [CrossRef]
- Michalaki, A.; McGivern, A.R.; Poschet, G.; Büttner, M.; Altenburger, R.; Grintzalis, K. The Effects of Single and Combined Stressors on Daphnids—Enzyme Markers of Physiology and Metabolomics Validate the Impact of Pollution. Toxics 2022, 10, 604. [Google Scholar] [CrossRef] [PubMed]

| Production Method | AgNPs Diameter | Tested AgNPs Concentration | Zone of Inhibition (ZOI) Diameter |
|---|---|---|---|
| Ultrasound pyrolysis (USP) | 115 nm | 300 mg/L | 6.34 mm |
| 150 mg/L | 6.15 mm | ||
| 3 mg/L | 5.59 mm | ||
| Batch LaSiS | 45 nm | 300 mg/L | 6.31 mm |
| 150 mg/L | 6.24 mm | ||
| 3 mg/L | 5.91 mm | ||
| Recirculatory LASiS | 12 nm | 300 mg/L | 6.45 mm |
| 150 mg/L | 5.86 mm | ||
| 3 mg/L | 5.72 mm | ||
| Commercial AgNPs (Positive control) | 10 nm | 20 mg/L | 7.15 mm |
| Deionised water (Negative control) | Not Applicable | 0 mm | |
Disclaimer/Publisher’s Note: The statements, opinions and data contained in all publications are solely those of the individual author(s) and contributor(s) and not of MDPI and/or the editor(s). MDPI and/or the editor(s) disclaim responsibility for any injury to people or property resulting from any ideas, methods, instructions or products referred to in the content. |
© 2023 by the authors. Licensee MDPI, Basel, Switzerland. This article is an open access article distributed under the terms and conditions of the Creative Commons Attribution (CC BY) license (https://creativecommons.org/licenses/by/4.0/).
Share and Cite
Manikandan, N.A.; McCann, R.; Kakavas, D.; Rochfort, K.D.; Sreenilayam, S.P.; Alkan, G.; Stornetta, T.; McGivern, A.R.; Grintzalis, K.; Friedrich, B.; et al. Production of Silver Nano-Inks and Surface Coatings for Anti-Microbial Food Packaging and Its Ecological Impact. Int. J. Mol. Sci. 2023, 24, 5341. https://doi.org/10.3390/ijms24065341
Manikandan NA, McCann R, Kakavas D, Rochfort KD, Sreenilayam SP, Alkan G, Stornetta T, McGivern AR, Grintzalis K, Friedrich B, et al. Production of Silver Nano-Inks and Surface Coatings for Anti-Microbial Food Packaging and Its Ecological Impact. International Journal of Molecular Sciences. 2023; 24(6):5341. https://doi.org/10.3390/ijms24065341
Chicago/Turabian StyleManikandan, N. Arul, Ronan McCann, Dimitrios Kakavas, Keith D. Rochfort, Sithara P. Sreenilayam, Godze Alkan, Tom Stornetta, Allan Robert McGivern, Konstantinos Grintzalis, Bernd Friedrich, and et al. 2023. "Production of Silver Nano-Inks and Surface Coatings for Anti-Microbial Food Packaging and Its Ecological Impact" International Journal of Molecular Sciences 24, no. 6: 5341. https://doi.org/10.3390/ijms24065341
APA StyleManikandan, N. A., McCann, R., Kakavas, D., Rochfort, K. D., Sreenilayam, S. P., Alkan, G., Stornetta, T., McGivern, A. R., Grintzalis, K., Friedrich, B., Foley, G., Brabazon, D., & Freeland, B. (2023). Production of Silver Nano-Inks and Surface Coatings for Anti-Microbial Food Packaging and Its Ecological Impact. International Journal of Molecular Sciences, 24(6), 5341. https://doi.org/10.3390/ijms24065341

